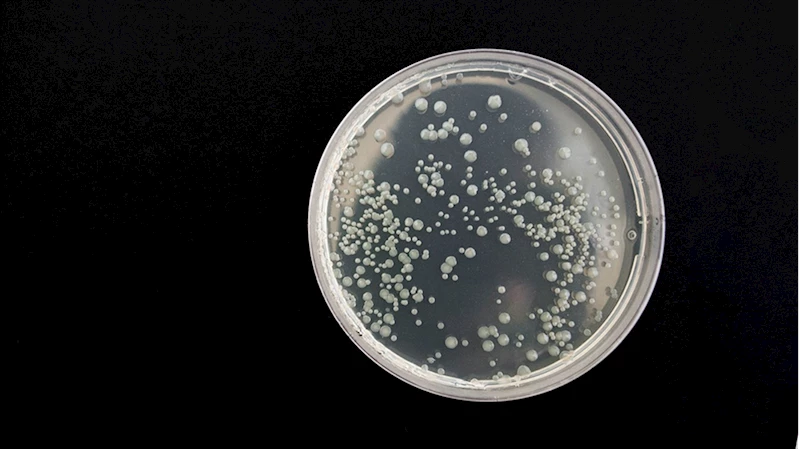

Bazı ölümcül bakteriler "vampir gibi" insan kanından besleniyor
Bazı ölümcül bakteriler "vampir gibi" insan kanından besleniyor
ANKARA (AA) - Washington Eyalet Üniversitesindeki (WSU) bilim insanları, kan dolaşımı enfeksiyonlarının oluşumunu incelerken bazı ölümcül bakterilerin insan kanındaki bir kimyasal maddeye yönelerek buradan beslendiğini ortaya koydu.
Araştırma lideri Siena Glenn, gıda kaynaklı salmonella, escherichia coli ve citrobacter koseri isimli 3 ölümcül bakterinin insan kanını hedef aldığına işaret ederek "bakteriyel vampirizm" özelliği gösteren tek hücreli bu mikroorganizmaların "vampir gibi" insan kanına eğilim gösterdiğini söyledi.
Bakterilerin özellikle bağırsak hastalığı olan kişilerde sindirim sistemindeki kesiklerden kan dolaşımına girebildiklerini kaydeden Glenn, bunların insan kanındaki maddeyi 1 dakika gibi kısa bir sürede tespit edebildiğini belirtti.
Glenn, bakterilerin kan kaynaklarına ulaşma şekillerini öğrendikten sonra buna uygun ilaç geliştirilebileceğini söyleyerek, bu ilaçlar sayesinde özellikle kan dolaşımı enfeksiyonu riski taşıyan insanların daha sağlıklı olabileceğini ifade etti.
İlgili araştırmanın sonuçları da "eLife" isimli bilim dergisinde yayımlandı.
Muhabir: Lejla Biogradlija
Cumhurbaşkanı Erdoğan, "Şüheda 1915" Tiyatro Gösterimi'ni izledi
Sanayi ve Teknoloji Bakanı Kacır: GÖKBEY, sivil yolcu taşıma sertifikasyonunu tamamlayan ilk milli hava aracımız oldu
ABD'de üretici enflasyonu şubatta beklentileri aştı
Merkez Bankası Para Politikası Kurulu Toplantı Özeti yayımlandı
Hakkari'de beyaz örtüyle kaplı dağlardaki kar manzarası dronla görüntülendi
UEFA Konferans Ligi'nde çeyrek finalistler yarın belli olacak
Suriyeli Abdülbari için 15 yıldır sakladığı evinin anahtarı "umudun başlangıcını" simgeliyor
Eminönü'nde bayram alışverişi hareketliliği
Diyarbakır'da "bayramda sofralar tatlansın" diye kadayıf üreticilerinden vardiyalı çalışma
Trump, Hürmüz Boğazı'nı ele geçirmeleri halinde "müttefiklerinin harekete geçeceğini" savundu
Almanya'daki Müttefik Hava Komutanlığınca görevlendirilen patriot sistemi Adana'da konuşlandırılıyor
ABD Başkan Yardımcısı Vance'in İran'a yönelik saldırılar konusunda sessiz kalması dikkati çekiyor
73 ildeki uyuşturucu operasyonlarında 958 şüpheli yakalandı
Trabzon'da terzi kardeşlerin ömrü dikiş makinesinin başında geçti
Milli futbolcu Kenan Yıldız: 4 yıldır buradayım ve burası bana büyük güven gösterdi
Afrika Uluslar Kupası şampiyonluğu iptal edilen Senegal kararı tahkime taşıyacak
Sakıp Sabancı Müzesi Resim Koleksiyonu yenilenen seçkisiyle açıldı
Özbek aileler ramazanda "ağız açar" iftar sofralarında bir araya geliyor
Depremzede anne, Türk Kızılay gönüllüsü olarak kız çocuklarına bayramlık dikti
Baharın müjdecisi leylekler Tunceli'deki köylerde bulunan yuvalarına dönmeye başladı
Kanoyla suda değil, Erciyes'te kar üzerinde süzüldüler
Hatay'da meslek liselilerin ürettiği çikolatalar bayramda ağızları tatlandıracak
Çanakkale Savaşları'nın bilinmeyen yönleri, Hisart Canlı Tarih Müzesi'nde sergileniyor
Kız kardeşler hayallerini sanat atölyesinde gerçeğe dönüştürdü
Sezonda 200 bin kişiyi ağırlayan Davraz Kayak Merkezi bayramı da hareketli geçirecek
"Saygınlar Kulübü" 65 yaş üstündekilerin buluşma adresi oldu
Kastamonu'da şehit öğretmen ve öğrencilerin hatıraları sınıftaki müzede yaşatılıyor
Tescilli Antep baklavasında üretim bayram için iki katına çıktı
SHURA'ya göre enerji güvenliği için ithal kaynak azaltılmalı, yenilenebilir yatırımları artırılmalı
AB, girişimcilere 48 saatte şirket kurma imkanı sunmaya hazırlanıyor
Yükleniyor






